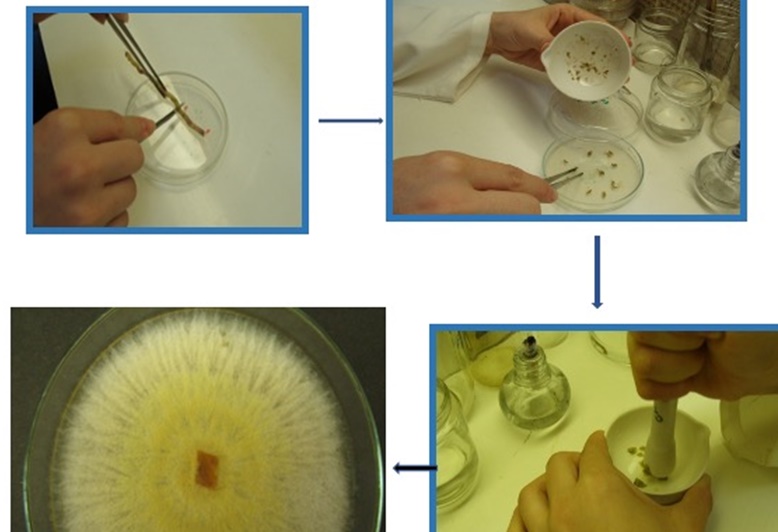

UFG descobre fungo que pode reduzir uso de agrotóxicos na agricultura
Governo federal vem flexibilizando o registro dos defensivos agrícolas mesmo diante dos alertas da OMS
Pesquisadores da Universidade Federal de Goiás (UFG) descobriram um fungo capaz de conter o avanço de pragas em plantações de arroz, tomate, soja e cana-de-açúcar – algumas das espécies mais cultivadas no País. O fungo tem potencial de causar uma pequena revolução na agricultura local, uma vez que o Brasil é hoje um dos principais mercados compradores de agrotóxicos ‘altamente perigosos’ do mundo, segundo um levantamento financiado pelo Greenpeace.
O estudo é conduzido pelo Laboratório de Genética de Microrganismos (LGM) do Instituto de Ciências Biológicas (ICB) da UFG. O nome do fungo é Waitea Circinata. Ele é retirado das raízes de uma orquídea do Cerrado.
“O fungo foi obtido a partir de três raízes de orquídea do cerrado. Primeiro avaliamos no laboratório e no arroz cinco doenças que foram controladas. Selecionamos duas doenças do arroz (brusone e queima da bainha) mais importantes, para avaliação nas plantas, cujo controle pelo fungo descoberto foi de 95% e 60%, respectivamente”, explica a professora Leila Garcês de Araújo, coordenadora da pesquisa.
“Para o controle destas doenças no Tocantins e no sul do Brasil utiliza-se até 18pulverizações de agrotóxicos que afetam a saúde humana causando câncer e o meio ambiente.Nas experiências com as plantas do arroz o controle destas doenças foi de 95% e 60%, respectivamente. No tomate houve controle de 83% da doença nematoide nas galhas, na cana e na soja, as pesquisas são promissoras e estão em andamento” reitera.
Novo produto
A pesquisadora explicou que para o desenvolvimento de um novo produto a partir deste fungo gasta-se em média 10 anos. “Fizemos a pesquisa, mas para chegar até o produtor rural e à nossa mesa foi feito um acordo de pesquisa entre a UFG e a empresa nacional de controle biológico em junho de 2020. Serão investidos R$ 486 mil para custeio, equipamentos, casa de vegetação e bolsas de estudos. Acreditamos que, em 5 anos, o produtor poderá usar para controle das doenças citadas.